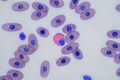

Z9やZ8の純正アイカップは比較的浅く、フィールドで使用していると、横からの迷光に対応できないことがあります。特に自分は夕方の日没前後に撮影することが多いため、シチュエーションによってはファインダーを見るのに支障が出ることがあります。
前回、UNX-8717を紹介しました。純正よりかなり深くなり、概ね満足ですが、より深くて真横からの迷光に完全に対応できる大型のアイカップが販売されたので試してみました。
JJCのアイカップ

大き過ぎではないかと思えるほど、かなり大型でマニアックな形状のアイカップです。こんな製品を作ったということは、やはり純正のアイカップが浅すぎるということで需要があったのでしょう。フィールドで同じアイカップを装着している人と遭遇したこともあるので、そこそこ人気があるようです。
つくりはしっかりしていて好感が持てます。
装着
専用設計なので、まったく問題なく装着できます。
UNX-8717はつぶしてコンパクトな形で使うこともできましたが、このアイカップはつぶすことはできません。眼鏡を使用している方には不向きでしょう。裸眼やコンタクトレンズ使用者向きです。
見た目はかなり大きく、最初は違和感を感じますが、慣れれば問題ないでしょう。
使用感

個人的には大変気に入りました。今まで試したアイカップの中では一番かもしれません。
個人差があると思いますが、顔の形状にフィットするので、迷光はほぼなくなります。そのため、ファインダーに集中することができます。
深い丸いアイカップは目玉を入れるような感じで、慣れるまで少し怖いような違和感を感じますが、この形状の大型アイカップは目を入れるのではなく、顔を押し当てるイメージなので、まったく違和感がありません。真横からの光も完全に遮断できるので、どんな状況でもファインダーがすこぶる見やすくなります。
アイピース上部には、ファインダーと液晶を切り替えるためのセンサーがありますが、誤作動することもなく、正常に動作します。
迷光に悩んでいる人はおすすめです。
ここまで大型ではない方が良い人にはUNX-8717をおすすめします。
追記
数か月使用して、より良さがわかってきました。
固くしっかりしたゴムなので、顔を押し付けてもあまり変形しません。この大型アイカップは眉あたりの出っ張り(眼窩上隆起)まで到達するほど大きいため、安心して顔に押し付けることができます。それによって、左手のレンズ、右手のボディグリップ、さらに顔面の三点で支える基本の構えがスムーズにできるようになります。手持ち撮影時の手振れ補正にも良さそうです。


| Amazon Link |
|---|
Nikon Z9、Z8、Zf専用アイカップ
|
Nikon Z9、Z8、Zf専用アイカップ
|
JJCによるNikon Z9、Z8、Zf専用のより深いアイカップです。 装着する事により、ファインダーを覗く際に横からの光の侵入をほぼ完ぺきに防いでファインダーを見やすくてくれます。 眼鏡使用者にはおすすめしません。 |
| Amazon Link |
|---|
カメラ関連
![]() Nikon Li-ionリチャージャブルバッテリー EN-EL18d Amazon |
![]() Nikon バッテリー室カバー BL-7 Amazon |
![]() Nikon FTZ II Amazon |
![]() SmallRig ニコンZ9用Lブラケット(ARCA SWISS互換) Amazon |
![]() グラマスGRAMAS Extra Camera Glass Nikon Z 9用 DCG-NI17 クリア Amazon |
メディア
標準ズーム
おすすめ![]() NIKKOR Z 24-120mm f/4 S Amazon |
![]() NIKKOR Z 24-50mm f/4-6.3 Amazon |
![]() NIKKOR Z 24-70mm f/2.8 S Amazon |
![]() NIKKOR Z 24-70mm f/4 S Amazon |
![]() NIKKOR Z 28-75mm f/2.8 Amazon |
広角ズーム
![]() NIKKOR Z 14-24mm f/2.8 S Amazon |
![]() NIKKOR Z 14-30mm f/4S Amazon |
![]() NIKKOR Z 17-28mm f/2.8 Amazon |
![]() NIKKOR Z 24-50mm f/4-6.3 Amazon |
単焦点レンズ
![]() NIKKOR Z 20mm f/1.8 S Amazon |
![]() NIKKOR Z 50mm f/1.2S Amazon |
![]() NIKKOR Z 85mm f/1.2S Amazon |
![]() NIKKOR Z MC 105mm f/2.8 VR S Amazon |
![]() NIKKOR Z 135mm f/1.8 S Plena Amazon |
望遠・超望遠レンズ
![]() NIKKOR Z 100-400mm f/4.5-5.6 VR S Amazon |
![]() NIKKOR Z 400mm f/2.8 TC VR S Amazon |
![]() NIKKOR Z 600/6.3 VR S Amazon |
![]() NIKKOR Z 800mm f/6.3 VR S Amazon |
野鳥撮影用おすすめ超望遠レンズ(Zマウント)
Zマウント純正テレコンバーター
![]() Z TELECONVERTER TC-1.4 Amazon |
![]() Z TELECONVERTER TC-2.0 Amazon |
野鳥撮影用おすすめ超望遠レンズ(Fマウント)
![]() AF-S NIKKOR 500mm f/4E FL ED VR Amazon |
![]() ニコン マウントアダプターFTZII Amazon |

Nikon Z9、Z8、Zf専用アイカップ